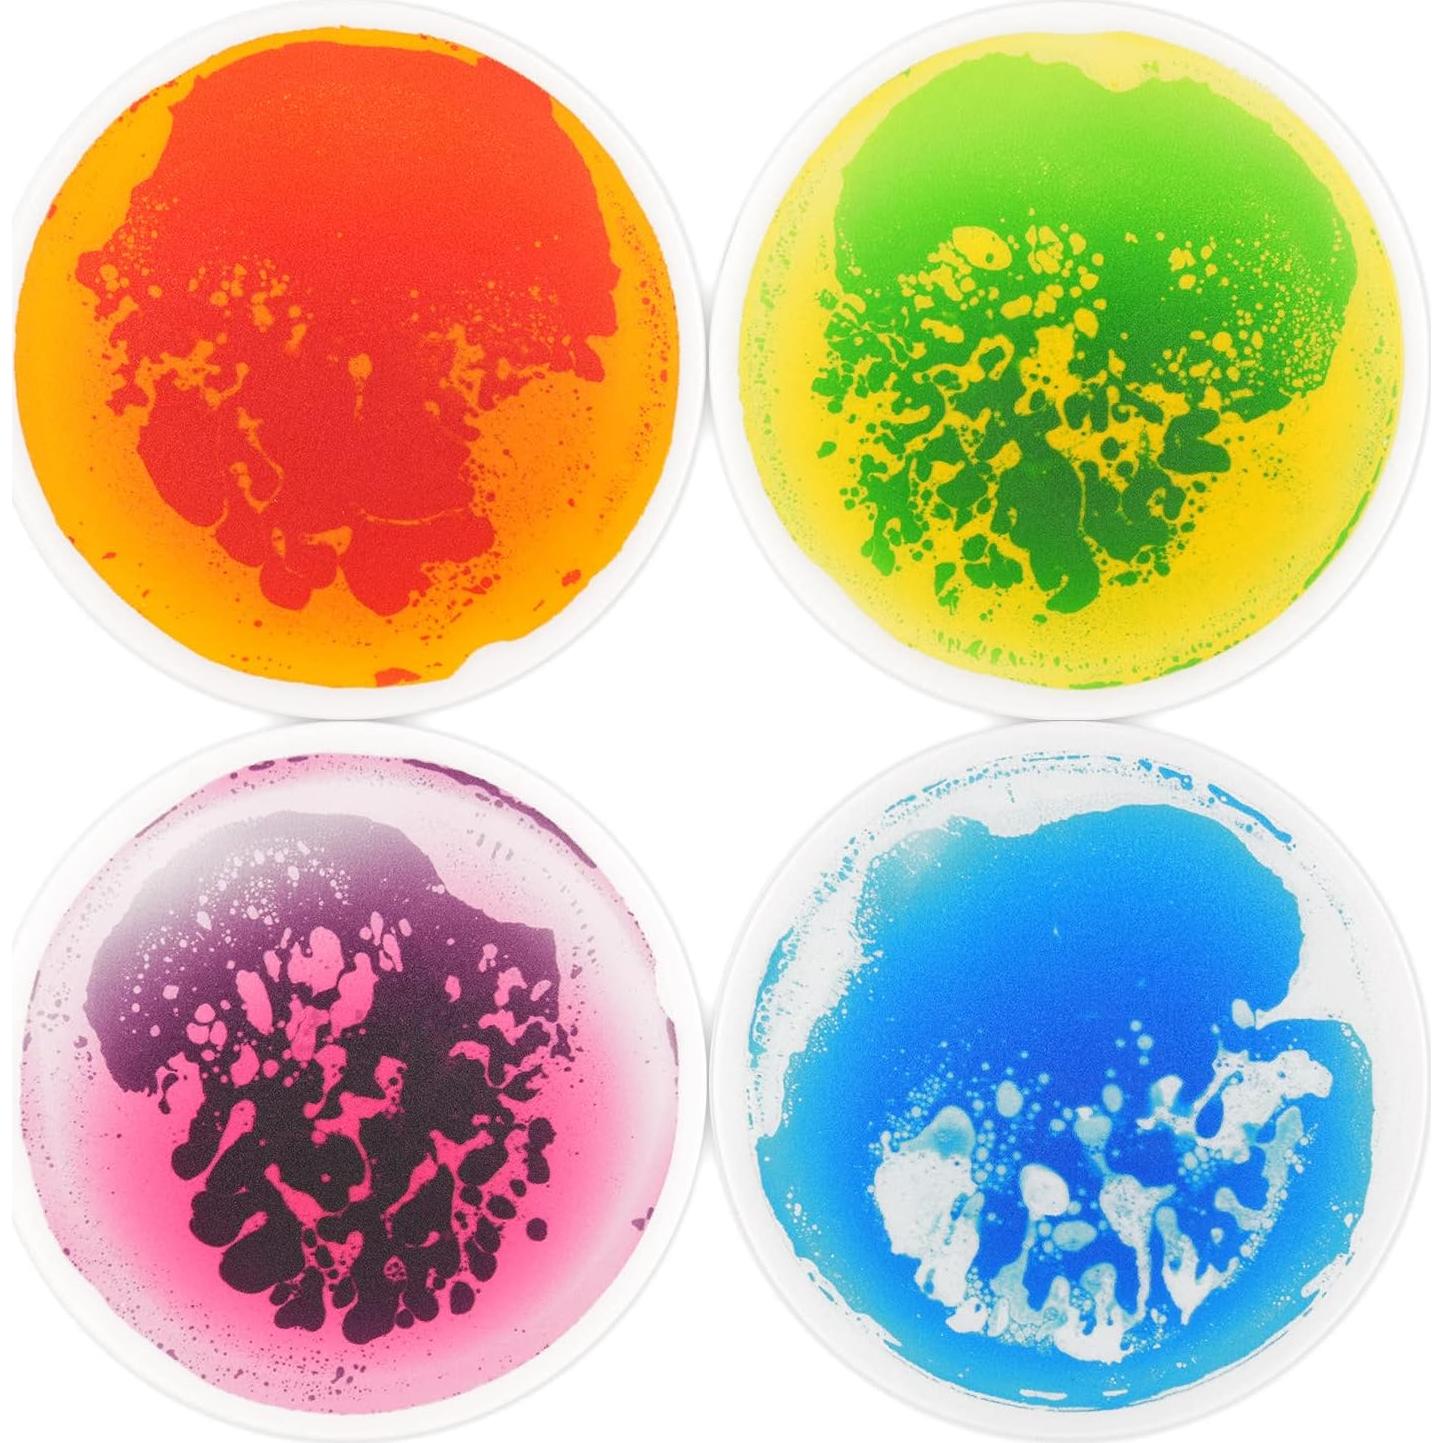
Baldosas Sensoriales Art3d 4 Pcs 30x30 cm Multicolor para Niños

PicassoTiles
Baldosas Sensoriales Art3d 4 Pcs 30x30 cm Multicolor para Niños

Baldosas Sensoriales Art3d 4 Pcs 30x30 cm Multicolor para Niños
$253.718
+ impuestos: $53.281
Llega a domicilio entre el 28 de feb y el 5 de mar
- Compra protegida
- Envío a todo el país
- Garantía de entrega
Características destacadas
- El líquido colorido se mueve con cada paso, salto o brinco. En una caja: 4 piezas de Baldosas de Suelo Líquido Cuadradas, el tamaño de cada baldosa es 30 cm x 30 cm.
- Divertidas Actividades Sensoriales: Colócalas en fila y corre a través de ellas o salta de una a otra, jugando, saltando o bailando alrededor.
- No se requiere instalación: se puede colocar en cualquier rincón de la casa, escuela, guardería, habitación de bebés o buena opción decorativa.
- Respaldo antideslizante: la capa de espuma antideslizante proporciona amortiguación y tracción para evitar resbalones. Bastante resistente y duradera, puede soportar el peso de los adultos.
- Uso recomendado: casa de juegos para niños / suelo de habitación infantil / pista de baile / tapete de juego / tiendas de moda / tapete para silla.
Opiniones de compradores
89 opiniones
Cheryl Wilson
Compré estos como regalo de Navidad y han resistido muy bien. Se juegan cada semana. Muy recomendados.
Nikki
¡A los chicos les encantan estos!
DENISE
Estamos usando estos para aprender a saltar, formas y colores. A mi pequeño le encantan y la estimulación sensorial que aporta es increíble.
Max Sigman
Soporta a adultos caminando sobre ellos y a niños saltando. Gran diversión para los más chicos.
Cynthia
A mis hijos de 4 y 2 años les gusta mucho esto.
Descripción
Especificaciones técnicas
- Fabricante
- Art3d
- Peso del artículo
- 1.92 kilogramos
- Dimensiones del producto
- 30 cm x 30 cm x 60 cm
- Número de modelo del artículo
- A11249
- Edad recomendada por el fabricante
- 3 años en adelante
Preguntas y respuestas
Tu pregunta fue enviada. Te responderemos pronto.
¿Dónde te enviamos la respuesta?
Tus preguntas
· Recibirás la respuesta a
Productos relacionados
PicassoTiles
Juego de 60 Piezas PicassoTiles 3D Magnéticos Educativos
Learning
Juego de Clasificación de Colores Learning Resources 31 Piezas
MelissaDoug






